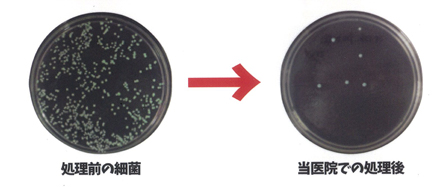

ピカッシュPicash
義歯を清潔に保つためにAg+(銀イオン)抗菌コーティング。
ピカッシュは、ナノ銀粒子をコーティングして義歯自体に高い抗菌力を持たせるものです。
市販の洗浄剤で洗浄・消毒しても再びお口に入れて使い始めるとすぐにバイ菌が増え始めます。
しかし、ピカッシュは義歯自体にコーティングをしているので、ナノ銀粒子がバイ菌を寄せ付けません!!
市販の洗浄剤で洗浄・消毒しても再びお口に入れて使い始めるとすぐにバイ菌が増え始めます。
しかし、ピカッシュは義歯自体にコーティングをしているので、ナノ銀粒子がバイ菌を寄せ付けません!!

ピカッシュの特徴
当院の患者様のみではなく、ご高齢のご家族のために義歯をお使いのご両親のためにと
ご家族の健康をお考えの方の勧めでご利用する方も増えてきました
ご家族の健康をお考えの方の勧めでご利用する方も増えてきました
1回3,000円(税別・保険適用外)で行なっております。





